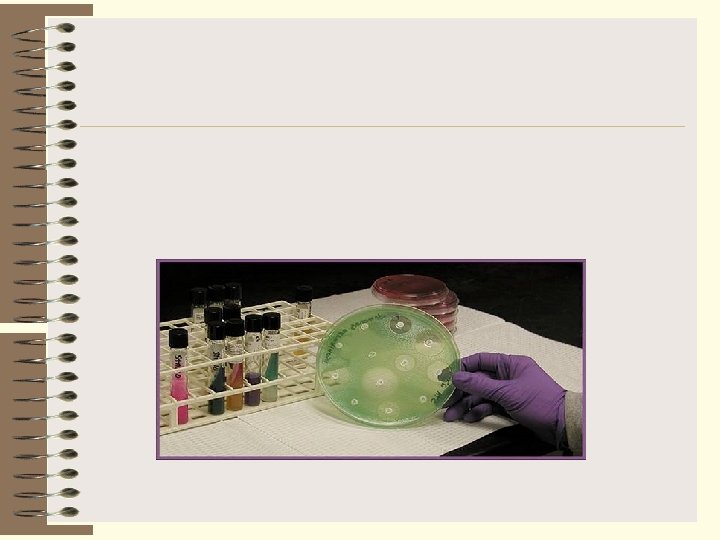

METHODS OF EXAMINATION IN MICROBIOLOGY BACTERIOSCOPIC BACTERIOLOGICAL SEROLOGICAL

METHODS OF EXAMINATION IN MICROBIOLOGY BACTERIOSCOPIC BACTERIOLOGICAL SEROLOGICAL BIOLOGICAL ALLERGIC EXPRESS-DIAGNOSIS

Clinical microbiology is the field of medical microbiology, which study microbial diseases in somatic departments of all specialties. There are general tasks, which provide the help to doctors in diagnosis, treatment and prophylaxis of purulent complications, before clinical microbiology

Features of purulent processes in non-infectious clinics: - polietiology; - non-specific clinical signs. There are more then 2000 causative agents of purulent diseases. The more frequent of them there are: - genera Prevotella; Staphylococcus, Streptococcus, Bacteroides, -families Enterobacteriaceae (Proteus, Klebsiella, Escherichia, Serratia, Citrobacter, Hafnia etc. ), Pseudomonadaceae, Neisseriaceae (Acinetobacter, Moraxella, Branchamella). In urological and gynecological Chlamydia. clinics - Mycoplasmas,

Most of conditionally pathogenic bacteria belong to normal human flora so it’s hard to determine their etiologic role (etiological significance). So, they can present normal microflora of tested fluids and tissues and contaminate them from environment. That’s why for correct interpretation of examination results it’s necessary to know composition of normal microflora of tested samples. In that cases if tested samples are sterile (blood, synovial and pleural fluids, liquor, exudates) all microbes which are present in them may be causative agents of diseases.

Bacteria Frequently Present as Normal Flora Occasionally Causing Overt Disease Organisms Usual Locale Infectious Disease Process Staphylococcus aureus Nose, skin In all areas of the body, nosocomial diseases, food poisoning Staphylococcus epidermidis Skin, nose, vagina Endocarditis, phlebitis, acne Enterococci Feces Blood, wounds, urinary tract, endocarditis Viridans streptococci Saliva Endocarditis Peptostreptococ- Mouth, cus sp vagina nosocomial feces, Abscess formation, gangrene Neisseria sp Throat, nose mouth, Meningitis Veillonella sp. Mouth, vagina Bacterial endocarditis, abscesses

Lactobacillus sp. Mouth, vagina feces, Bacterial endocarditis lung abscess (1 report) (rare), Corynebacterium sp. Nasopharynx, skin, vagina Mycobacterium (not Mycobacterium tuberculosis) Prepuce, clitoris, Suspected in some infectious lung, feces, disease processes tonsils, Food, skin Clostridium sp. Feces, skin, Clostridia myositis, cellulitis, environment, food poisoning including food, Vagina Bacterial endocarditis Enterobacteriaceae Feces, vagina, Urinary tract, wounds, mouth, urethra pneumonia, nosocomial scesses, meningitis, blood, peritonitis, enteritis, abscesses, etc. Moraxella sp. Nose, genito- Conjunctivitis, etc urinary tract

Achromobacter sp. Nose, genitourinary tract, skin Meningitis, burns blood, urethritis, Pseudomonas sp. Feces, skin Blood, burns, wounds, urinary tract, respiratory tract, meningitis Alcaligenes faecalis Feces Blood, urinary tract, conjunctiva, respiratory tract, meningitis Haemophilus sp. Nasopharynx, conjunctiva, vagina Laryngotracheobronchitis, meningitis, pyarthrosis, conjuncti vitis, genitourinary tract Fusobacterium sp. Mouth, saliva, Infected human bites, gangrene feces Bacteroides sp. Feces, throat mouth, Bactenal endocarditis, abscesses, mixed infections

Pure culture of conditionally-pathogenic microbes may be causative agents of disease according to the such signs: - microbes are present in tested material from pathologic focus in the amount of 104 -105 colony-forming units (CFU) in 1 ml or 1 g; - repeated isolation from the same material the same culture; - increasing in the patient’s serum antibodies to the autostrains or microbial culture, which can be causative agent.

There are necessary roles before collection of tested material: - to take material before antibacterial therapy beginning or after some time after antibiotic inoculation which is necessary for its excretion from the organism (as a rule 8 -10 hours); - to take material from infectious focus or examine proper discharges; - hold on to the strict aseptic for the purpose to prevent contamination of the specimen by microflora of environment;

- material is taken into the sterile boxes; clinical specimen with anaerobic bacteria must be protected from atmosphere oxygen action; - the collection of an adequate specimen is useless if the time between collection and culturing allows the diseaseproducing organism to die (in another cases it’s necessary to use the refrigerator or special transport media); - isolation of viruses, Rickettsia, Chlamidia is made in specialize laboratories; - to clinical specimen a proper document is added, which has data for correct microbiological examination.

Examination of the blood Bacteriemia, septicopyemia

Bacteremia — bacteria in the blood — frequently is accompanied by the onset of chills and fever, an increase in pulse rate, and a drop in blood pressure. Even in infections in which bacteremia is a major aspect of the disease, the organisms in the bloodstream are not always constantly present in sufficient numbers to be grown from a single blood specimen. Patients with such infections may have to provide several blood specimens before the causative agent can be isolated. When an intermittent bacteremia is suspected, it is routine to obtain three 10 to 20 -ml blood samples over a 24 hour period to maximize chances for isolation of the organism

Collection of a Blood Specimen In taking a blood specimen for culture, one should be aware that although blood is normally sterile, the skin that must be penetrated is not sterile. Routinely, the skin should be cleansed first with 70% to 95% alcohol to remove dirt, lipids, and fatty acids. The site then should be scrubbed with a circular, concentric motion (working out from the starting point) using a sterile gauze pad soaked in an iodophor. The iodine should be allowed to remain on the skin for at least 1 minute before it is removed by wiping with a sterile gauze pad soaked with 70% to 95% alcohol. It must be emphasized, however, that all this will be useless if the person drawing the blood palpates the vein after the cleaning process, thereby contaminating the very site that had been cleaned. After cleansing the penetration site, the blood can be withdrawn using either a sterile needle and syringe or a commercially available, evacuated blood collection tube.

Media Inoculated With Blood Specimens Blood always should be inoculated into the appropriate medium at the bedside partially evacuated, commercially available, blood culture bottles, which contain 30 to 100 ml of a rich, liquid medium such as brain-heart infusion or trypticase soy broth is routinely used. If possible, 10 to 20 ml of blood should be taken from the patient and inoculated into an approximately 10 fold excess of the blood culture medium when possible, two such bottles should be inoculated. One is vented to permit the growth of aerobic bacteria (by inserting a sterile, cotton plugged needle through the rubber stopper until the bottle has filled with air), and the other is not vented to allow the growth of anaerobic organisms. Special media for aerobic and anaerobic culture available. Some commercially available bottles are provided with a venipuncture set, which allows the blood to be injected into the medium.

Identification of Blood Isolates Blood cultures are incubated at 36°C and observed daily for at least 1 week for evidence of turgidity or hemolysis. Gram's stains, streak plates, and antibiotic susceptibility tests should be carried out as quickly as possible after the observation of visible growth in the original broth culture. In the absence of obvious growth in 1 or 2 days, blind subcultures on chocolate blood agar plates may speed the appearance of obligately aerobic organisms. Commercially available penicillinase can be added to blood cultures from patients who have received penicillin therapy. Penicillinase preparations should be checked for sterility to eliminate them as a potential source of contamination. Resins incorporated in special blood culture media can neutralize a broad spectrum of antibiotics.

Once a Gram's stain has rendered some information concerning the type of organism involved, special supplementary or differential media should be inoculated. Mac. Conkey or eosin-methylene blue plates should be streaked if gram negative rods are present, and prereduced media should be inoculated if obligate anaerobes such as Bacteroides or Fusobacterium are suspected. The finding of organisms that constitute the normal flora or are frequent inhabitants of the skin (eg, diphtheroids, Staphylococcus epidermidis. Bacillus sp. ) usually is viewed with suspicion, unless the frequency of isolation or the clinical setting indicates they did not arrive as contamination during the collection of the blood

Pathogenesis of toxic shok

If microbes are absent after 10 days of incubation it means, that inoculation results are negative and blood is sterile.

URINE Most urinary tract infections are initiated by organisms that gain entrance to the bladder by ascending through the urethra, and they are more common in women than in men In men, however, a chronic infection of the prostate gland also can be the source of a bladder infection (cystitis) or a kidney infection (pyelonephritis). In both sexes, most urinary tract infections are caused by normal flora enteric organisms, among which can be species of Escherichia, Klebsiella, Fnterobacter, Proteus, Pseudomonas, and Enterococcus.

Examination of urina Etiology of urethritis

Major causes of urinary tract infections

Pathogenesis of genital tract infections

Major causes of vaginitis Major causes of cervicites

Collection of Urine Specimens Urethral catheterization can yield samples with minimal contamination, but the danger of introducing organisms from the urethra into the bladder provides some risk to this procedure. Moreover, microbial flora in the urethra, particularly in men, can contaminate the specimen, leading the microbiologist to an erroneous conclusion. Therefore, catheterization is not performed routinely for the collection of urine samples. Instead, voided samples are obtained after careful cleansing of the external genitalia. However, the following considerations must be adhered strictly if bacteriologic reports on voided urine samples are to be meaningful.

First, all voided urine samples will contain some bacteria, therefore, a quantitative assay for the number of bacteria present must be carried out. Second, this number will be grossly misleading unless the exterior genitalia are carefully cleaned to remove contaminating bacteria from the female vulva and perinea area and from the male urethral meats. The patient must be carefully instructed in how to wash these areas with soap and water, then rinse them thoroughly to remove any residual soap. Women must be instructed to keep the labia continuously apart during the washing, rinsing, and voiding of urine. Urine from either sex should be collected in a sterile cup only after the first 20 to 25 ml has been voided, because the flushing action of the initial flow will remove many of the organisms present in the urethra.

Media Inoculated With Urine Specimens All voided urine samples, as well as most samples collected by catheterization, contain some bacteria, so the clinical diagnosis of an infection is based on the numbers of bacteria in the urine. Considerable experimental data have resulted in the formulation of the following rules: (1)101 bacteria or more per milliliter from a clean, voided specimen indicates a urinary tract infection; (2) a value of 101 to 104 bacteria per milliliter in a symptomatic patient requires a second culture, and (3) 103 or fewer bacteria per milliliter usually is not considered significant in a voided sample. Single samples cannot be considered to be 100 % accurate, and it frequently is advisable that duplicate samples collected at different times be sent to the diagnostic laboratory. Because of the need to measure the bacteria present in a sample of urine, several different techniques have been devised to accomplish a rapid enumeration.

A standard platinum dilution loop (commercially available) holds about 0. 001 ml of liquid. Such a loop can be used to streak a urine specimen directly onto a nutrient-agar plate. If the loop is calibrated monthly and compared with counts obtained by the pour plate method, the overall accuracy of the calibrated loop technique is equivalent to that of a pour plate. A variety of screening kits are commercially available for suspected urinary tract infections. One, called a paddle or dip slide type, has a selective agar medium coated on one side and a nonselective agar medium on the other side. The paddle is dipped into the urine specimen, reinserted into its sterile container, and incubated at 35°C for 18 to 24 hours become counting the colonies (Fig. ). The amount of urine adhering to a paddle has-been determined experimentally by the manufacturer, and this kit is reported to be about 95% as accurate as the pour plate procedure. Other kits also are available, and it is likely that each laboratory has its preferred method for enumerating the microorganisms present in a urine specimen.

Gold’s streak

Evaluation creteria: 1. Bacteriuria degree not more then 103 CFU/ml of urine testifies the absence of inflammatory process. It is contamination of urine. Bacteria in the same amount which are found in the urine testify about chronic persistent infection. 2. Bacteriuria degree 104 CFU/мl testifies doubtful result. Examination must be repeated. 3. Bacteriuria degree 105 CFU/ml testifies the availability of inflammatory process. 4. Changes of bacteriuria degree during disease may be used for control of the disease and therapy effectiveness.

Identification of Urine Isolates If a speedy result is required, a Gram's stain of the uncentrifuged urine specimen can be examined, primarily because if one drop is allowed to dry on a slide without spreading, the appearance of one or more bacteria per oilimmersion field (sometimes with leukocytes present) is indicative of a total bacterial count greater than 10 microorganisms per milliliter of urine. Blood-agar plates, as well as Mac. Conkey and eosinmethylene blue plates, should be streaked with the urine specimen. Because members of the Enterobacteriaceae are, by far, the most frequent causes of urinary tract infections.

CEREBROSPINAL FLUID Etiology of meningitis

The usual clinical signs of meningitis are headache, fever, vomiting, and a stiff neck; however, many of these signs can be absent, or not evident, in infants. There are several specific organisms that are frequent causes of meningitis, namely N. meningitidis, H. influenzae, and S. pneumoniae. In addition, other organisms, such as M. tuberculosis and Cryptococcus neoformans, less frequently cause meningitis. Essentially any organism that gains entrance to the fluid surrounding the brain and spinal cord can grow and causes inflammation of the menings. Such infections frequently are severe and, unless promptly and adequately treated, can result in the death of the patient in a matter of hours.

Specimen Collection of Cerebrospinal Fluid Cerebrospinal fluid (CSF) is obtained by a puncture into the lumbar region of the spine. It is of utmost importance that the puncture site be decontaminated in the manner described previously for venipunctures to ensure that no contaminating organisms are mechanically injected into the CSF. The collected specimen should be placed into a sterile screw-cap tube and delivered immediately to the diagnostic laboratory.

Media Inoculated With Cerebrospinal Fluid A diagnosis of meningitis usually is based on the microbiologic findings in the CSF, chemical determination of the total protein and glucose present in the fluid, and its cellular content. Because the total specimen frequently is only 1 to 2 ml. , the sample must suffice for the haematology, chemistry, and microbiologic findings. Therefore, after the cell count, the CSF is routinely centrifuged for 10 minutes at 1200 times gravity; part of the supernatant is used for the chemical assays, and the sediment is the source for the bacteriologic evaluation. The sediment from the centrifuged sample is inoculated onto one blood and one chocolate blood-agar plate. Both plates are incubated aerobically under 5% to 10% CO 2 at 35°C, and disks of hematin and NAD are added to allow the growth of H. influenzae. Another method of providing these required factors is to make a single streak of S. aureus across the plate. The staphylococci release these factors by lysis of the red blood cells in the agar, and H. influenzae will be found growing only as satellite colonies adjacent to the growth of the staphylococci. The chocolate-agar plate is incubated under an atmosphere of 10% CO 2. Both nutrient broth and a special broth for the growth of anaerobes should be inoculated with the CSF sediment. All cultures should be inspected daily and, in the event of growth; broth media should be subcultured onto an appropriate agar medium.

Identification of Isolates from Cerebrospinal Fluid Because meningitis frequently presents an emergency situation, it is imperative that a tentative diagnosis is made as soon as possible. It is mandatory that the sediment from the centrifuged CSF be subjected to Gram's stain and examined microscopically. Because the number of organisms often is small, it is recommended that at least 30 minutes be spent for such an examination. If organisms are seen, additional procedures sometimes can be used to substantiate immediately a tentative identification. The most common of these are to carry out a coagglutination reaction using latex beads with known specific antiserum or to stain with specific, fluorescence -labelled antiserum. Capsular antigens of certain streptococci, N meningitidis, and H influenzae can be present even in the absence of bacteria on the Gram's smear, and using latex bead agglutination procedures may speed up the diagnosis of meningitis.

Spinal fluid from a possible case of tuberculosis meningitis should be stained for acid fast organisms, and a possible infection by C. neoformans can be diagnosed tentatively using wet mounts of spinal fluid sediment mixed with India ink or nigrosin to demonstrate the large capsules surrounding the yeast cells. A latex bead test for cryptococci also is available. An evaluation of a patient's inflammatory response also aids in the diagnosis of a meningeal infection. In general, polymorphonuclear leukocytes predominate in the CSF in acute bacterial infections, whereas meningitis resulting from fungi, Leptospira, or M. tuberculosis is characterized by the presence of lymphocytes.

RESPIRATORY TRACT AND MOUTH


Because of the myriad normal resident flora in the upper respiratory tract, the isolation of lower respiratory tract infectious agents can be difficult and contusing. This is complicated further by the occasional presence of small numbers of potential pathogens such as pneumococci, meningococci, streptococci, Staphylococcus aureus, Haemophilus influenzae, or enteric organisms that are indigenous to the upper respiratory tract.

Specimen Collection From the Respiratory Tract The microbiologist must be certain that lower respiratory tract specimens represent sputum that has been brought up by a deep cough. However, it may not be possible to obtain a good sputum sample from a young child, a debilitated older person, or someone who is comatose. In such situations, other procedures must be carried out to obtain a specimen from the lower respiratory tract. One technique is transtracheal aspiration, which, as shown diagrammatically in Figure 1, uses a needle and tube inserted into the trachea. This technique also overcomes the problem of contamination from the oropharynx. On some occasions, sterile saline solution is injected through the tube before aspiration.

Transtracheal aspiration A pillow should be placed beneath the neck to permit maximum extension or the neck. After cleansing the skin, a 14 gauge needle is inserted into the trachea, and a polyethylene tube is passed through the needle into the lung 1 he needle is withdrawn, and the tube is connected to a syringe containing 3 ml to 4 ml of physiologic saline. The saline is injected into the lung and immediately with drawn for culture.

Media Inoculated With Respiratory Tract Specimens All throat swabs should be kept moist until delivered to the laboratory. Special media are used for the isolation of specific pathogens, and the laboratory should be informed by the clinician what range of pathogens is possible. For instance, sheep blood-agar plates are sufficient for the isolation of -hemolytic streptococci, but S. aureus, Streptococcus pneumoniae and Neisseria meningitidis grow better on chocolate blood agar in the presence of excess CO 2; A suspected C diphtheriae would be inoculated additionally on a Loeffler's coagulated-serum slant and a potassium tellurite-agar plate. To isolate and identify Bordetella pertussis from a suspected case of whooping cough, special medium would be inoculated from a swab.

A swab containing a possible H. influenzae would be streaked on a chocolate-blood agar plate. Thick sputum that is to be cultured for Mycobacterium tuberculosis usually is thinned by digestion in 4% Na. OH and a mucolytic agent at 37°C for 1 hour, followed by high-speed centrifugation (2000 times gravity for 30 minutes). Other digestion procedures also have been reported. These procedures result in a concentration of the tubercle bacilli and the destruction of most contaminating organisms. It should be recognized that these digestion procedures also destroy the tubercle bacilli, and the time and temperature should not be extended beyond the recommended limits. After centrifugation, sediment material can be used to inoculate media, such as Lowenstein-Jensen medium.

ORGANISMS COMMONLY ISOLATED FROM RESPIRATORY TRACT SAMPLES AND SPECIALISED PROCEDURES USED FOR THEIR IDENTIFICATION Organism Special Procedures Streptococcus group Sensitive to commercially available bacitracin A hemolytic disks, catalase negative, fluorescently-labelled antibody or conglutination Streptococcus pneumoniae Sensitive to optochin disks; lethal for mouse in 18 hours Staphylococcus aureus Vogel Johnson medium; ferments mannitol; (coagulase positive) Haemophilus influenzae Streak blood plate and check for hematin and NAD requirement Neisseria meningitides Grow in Thayer Martin medium Bordetella pertussis Bordet-Gengou agar plates Corynebacterium diphtheriae Loeffler's coagulated serum and potassium tellurite plates

Organisms causing upper respiratory tract infections that may cause lesions in the throat should be obtained with a cotton swab and streaked on a suitable medium as soon as possible or used for direct antigen detection. Nasopharyngeal cultures usually are obtained with a cotton swab on a bent wire, which can be passed through either the nose or the mouth, carefully bypassing the tongue and oropharynx. Nasopharyngeal cultures are especially important for detecting carrier states for meningococci, Corynebacterium diphtheriae, group A - -hemolytic streptococci, and H influenzae. The last organism also can cause an acute epiglottitis, but initial treatment for that infection is based on clinical evaluation and must be initiated before laboratory isolation would be possible.

Identification of Respiratory Tract Isolates The appearance of the colony on sheep blood agar and the use of the Gram’s stain are the most powerful tools available for a presumptive identification of a potential pathogen. If tuberculosis is suspected, acid-fast stains should be made on the centrifuged sediment obtained from the sputum digestion procedure. Many other specialized procedures are available, and the choice depends on information received from the clinician and on the appearance of the initial isolates. Fluoresceinlabelled antibody or latex particles with attached antibody directed against group A streptococcus provides rapid identification of these organisms.

WOUNDS AND ABSCESSES Pus and exudates from an infected wound or open abscess would be expected to contain the etiologic agent of the infection. However, in open wounds, skin and soil contaminants almost invariably are found that, under appropriate growth conditions could outgrow the true infectious organism, resulting in an erroneous laboratory report.

Skin infection

Infections in which anaerobes are the predominant pathogens or are commonly present Region Type of Infection Head and neck Brain abscess, Otogenic meningitis extradural or subdural, Empyema, Chronic otitis media, Dental infection Pleuropulmonary Pneumonia secondary to obstructive process, Aspiration pneumonia, Lung ahscess, Bronchiectasis, Thoracic empyema Intraabdominal Liver abscess, Pylephlebitis , Peritonitis, Appendicitis, Subphrenic abscess, Wound infection after bowel surgery or trauma, Liver abscess Female genital Puerperal sepsis, Postabortal sepsis, Endometritis, Tuboovarian abscess Other Perirectal abscess, Gas forming cellulitis, Gas gangrene, Breast abscess

Collection of Specimens from Wounds and Abscesses Whenever possible, a sterile syringe and needle should be used to collect specimens from wounds and abscesses. The use of a swab is routinely unsatisfactory because of the limited amount of material collected by this method, making it difficult or impossible to isolate the etiologic agent or agents. It also is important to remember that wounds and abscesses arc commonly infected with obligately anaerobic bacteria, which quickly die on a swab that are exposed to the atmosphere. Therefore, all aspirates should be transported to the laboratory in special tubes containing oxygen-free gas. Such containers, which can be obtained commercially, usually contain a few drops of 0. 0003% resazurin, an oxidation-reduction indicator that turns pink if air contaminates the bottle. Burns often are infected with opportunists such as Pseudomonas aeruginosa, enteric organisms, and staphylococci, and yeast, make isolation of the definitive infectious agent extremely difficult. Quantitative cultures may assist in the interpretation of laboratory findings. Specimens of burned tissue and any drainage material should be sent to the laboratory for culture and evaluation.

Media Inoculated With Wound and Abscess Specimens In general, obligate anaerobes, such as those in the genera Clostridium, Bacteroides, Eubacterium, Fusobacterium, and Actinomyces, must be considered. Numerous specialised media can be used successfully for the growth of the obligate anaerobes. Most contain whole or lysed blood from sheep, complex infusions such as brain-heart infusion or chopped meat, vitamin supplements such as yeast extract and additional vitamin K, and, in broths, a reducing agent such as thioglycolate or cysteine with 0. 1% agar added to reduce convection cur-rents. Because most wound infections or abscesses contain multiple organisms, the use of liquid media alone is not satisfactory. In fact, if isolated colonies are obtained on agar plates, little is gained by the examination of broth cultures. However, agar plates must be incubated in an anaerobic jar (a jar from which all oxygen has been removed) or a similar device. Because most infections are caused by mixtures of aerobic and anaerobic bacteria, blood-agar plates as well as selective and differential media (eg, eosin-methylene blue or Mac Conkey) also must be inoculated and then incubated aerobically at 36°C.

Identification of Wound Isolates The multiplicity of genera that can be found in a wound makes it difficult to list firm rules for their identification. A Gram's stain of all specimens should be observed first. The results of microscopic examination may provide information that will aid in a decision regarding which media should be inoculated and under what conditions the culture should be incubated. It is no simple affair to differentiate between the true etiologic agents of wounds and abscess infection and the contaminants that “go along for the ride”.

Criteria of microbial growth evaluation (streak with tampon onto plate agar): І – very poor growth – growth only in liquid media, on plate agar growth is absent; ІІ – small growth - about 10 colonies; ІІІ – moderate growth – 11 - 100 colonies; IV – great growth – more then 100 colonies. І-ІІ degree - contamination, ІІІ-IV - etiological significance of real microbe. Contamination level 105 CFU/g is critical, it testifies the role of bacteria in development of infectious process.

FECES Gastrointestinal illnesses usually are characterized by diarrhea or the presence of blood, mucus, and, in certain cases, white blood cells in voided stools. Many such disturbances are cases of food poisoning resulting from the ingestion of a preformed toxin. Symptoms of such intoxication rarely last beyond 24 hours, and treatment usually is confined to the intravenous replacement of lost fluids and electrolytes.

A bacteriologic examination of food suspected of causing an illness would be more likely to yield informative data concerning the etiology of intoxication than would an examination of a faecal specimen. For example, a Gram's stain revealing large numbers of staphylococci, together with a history and the clinical symptoms of staphylococcal food poisoning, would provide strong circumstantial evidence that the gastroenteritis was due to the ingestion of food contaminated with staphylococcal enterotoxin.

A similar situation would be seen in food poisoning due to Clostridium perfringens. In both cases, the organisms would be present in large numbers in the contaminated food; however, because the staphylococcal enterotoxin is more stable to heat inactivation than are the staphylococci themselves, it would not be unusual to see large numbers of staphylococci in a Gram's stain (of a heated cream soup) and yet not be able to culture significant numbers of organisms from the suspected food. On the other hand, because the C. perfringens enterotoxin is produced only during sporulation, large numbers of viable organisms might be found in a similar situation. It is likely that many cases of gastroenteritis are of viral origin.

Concentration of microbes in human digestive tract

Main group of bacteria in the gut Anaerobic bacteria Bacteroides (B. fragilis), Prevotella, Veilonella, Lactobacillus (L. acidophylus, L. brevis), Clostridia (C. perfringens, C. tetani, C. botulinum, C. sporogenes), Peptococcus, Peptostreptococcus, Actinomyces Aerobic and facultativly anaerobic bacteria E. coli, Enterococcus, Citrobacter, Klebsiella, Proteus, Providencia, Pseudomonas, Alcaligenes, Bacillus (B. subtilis, B. Brevis), Lactobacillus, Enterococcus, Corynebacteria, Fungi, Candida

Specimens from Intestinal Contents In culturing intestinal contents, the choice of material to be taken from the patient is obvious, although best results are obtained when the faecal specimen is collected during the acute stage of an episode of diarrhea. If a specimen contains blood or mucus, these should be included in material to be sent to the laboratory. When a sterile swab is used instead of a faecal specimen, the swab must be inserted past the anal sphincter and rotated several times before being withdrawn.

It is a common misconception that the microorganisms found in faeces are rather hearty and those special precautions to preserve the viability of suspected pathogens are not required. Nothing could be further from the truth! Unless faecal specimens can be taken directly to the laboratory for culturing, they should be refrigerated or placed in a stool preservative containing a buffer that will maintain the p. H near neutrality. One such preservative uses about equal parts of sterile glycerol (containing 0. 033 M phosphate buffer, p. H 7. 4) and faeces. A p. H indicator also can be included to ensure that a drop in p. H does not go unnoticed. Failure to use a preservative will result in the death of many of the enteric pathogens, especially the Shigella and, to a lesser extent, the salmonellae. Faecal specimens of l to 2 g are adequate for bacteriologic procedures.

Media Inoculated With Intestinal Specimens The major intestinal flora consists of obligately anaerobic gram negative rods, including organisms in the genera Bactericides, Fusobacterium, Eubacterium, and Clostridium. All these can cause serious abscesses but, with the exception of the enterotoxins from C perfringens and Clostridium difficile, none of the obligate anaerobes has been implicated in gastrointestinal disease characterized by diarrhea. Therefore, unlike the processing of blood or abscess specimens, it is not usual to culture faecal specimens under anaerobic conditions.

When species of either Salmonella, or Shigella are the possible pathogens, it is advisable to inoculate an enrichment medium that will selectively permit the growth of these organisms over that of the normal gram-negative flora. Many such media are available, and it is probable that some diagnostic laboratories use various modifications of these media. Two of the more common enrichment media are a tetrathionate and a selenite F medium, both of which arc commercially available. After incubation of the inoculated enrichment medium for 12 to 16 hours at 35°C to 37°C, it should be streaked on standard, differential media such as Mac. Conkey or eosin-methylene blue and deoxycholate agar plates. Hektoen enteric or xylose-lysine-deoxycholate plates also can be used. Many other differential and selective media are available that can be used for the isolation of the pathogenic Enterobacteriaceae, and it is likely that diagnostic laboratories vary somewhat in their preference of one medium over another

Identification of Fecal Isolates Because of the large numbers of facultative, gram negative rods that make up the normal intestinal flora, the isolation and identification of the morphologically similar Shigella and salmonellae requires the use of selective and differential media as well as considerable experience in working with these organisms. As outlined, numerous kits are available for use in identifying members of the Enterobacteriaceae. One widely used kit, termed the API 20 E, consists of a plastic strip containing wells of dehydrated media and appropriate indicators. The wells are inoculated with a suspension of the unknown organisms and, after 24 hours, a numerical value is assigned to each positive reaction. Using the sum of these values, a complete identification can be made from tables that accompany the kit.

The identification of staphylococci from a faecal specimen is i moderately easy task it the laboratory has been instructed that the clinical symptoms are compatible with those of a staphylococcal enteritis Large colonies on selective sheep blood agar plates showing Fs hemolysis and grape like clusters of gram positive cocci should be tested additionally for coagulate production and, if specific antiserum is available, for the production of enterotoxin. Intestinal infections by yeast, such as species of Candida, or any of the many parasitic protozoa worms are diagnosed by the direct microscopic examination of a faecal specimen.
- Slides: 65